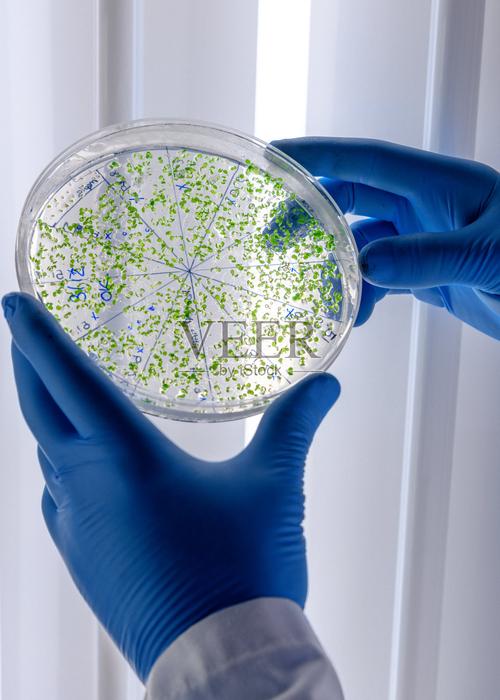

今天给各位分享空气培养皿需要放置多长时间呢的知识,其中也会对空气培养皿需要放冰箱吗进行解释,如果能碰巧解决你现在面临的问题,别忘了关注本站,现在开始吧!
空气培养皿放几分钟
空气培养皿需要放置的时间如下:开皿暴露时间:空气培养皿在三类环境空气培养标准下,开皿后需要暴露5分钟。培养时间:暴露后,按照标准空气培养规范进行计算,培养皿需要在适宜的培养条件下放置48小时,之后进行读数。空气培养皿是用于微生物或细胞培养的实验室器皿,其正确的放置时间是确保培养结果准确性的重要因素。
(图片来源网络,侵删)
空气培养皿需要开皿后暴露5分钟,然后培养48小时后进行读数。具体解释如下:暴露时间:空气培养皿在三类环境空气培养标准下,需要开皿后暴露5分钟。这是为了让空气中的微生物充分沉降到培养皿的培养基上。培养时间:暴露后,将培养皿盖好并进行培养,一般需要培养48小时。
培养时间:标准培养时长:暴露完成后,培养皿需要被密封并放置在适当的培养条件下进行培养。按照标准空气培养规范,培养皿需要培养48小时。这一步骤是为了让沉降到培养基上的微生物有足够的时间进行生长和繁殖,以便后续能够准确地进行计数和鉴定。
离地高度大于八十厘米,离墙距离大于一米。空气培养皿的正确摆放为离地高度大于八十厘米,离墙距离大于一米。面积小于三十平方米的取一条直线,前,中,后分别放置三个空气培养皿。面积大于三十平方米的,取四个角及中央放置五个空气培养皿。三类环境开盖放置五分钟,二类环境开盖放置十分钟。
(图片来源网络,侵删)
空气培养皿需要放置5分钟。在进行空气培养之前,需要将室内环境准备好,并确保采样时没有人走动。采样结束后,盖好玻璃培养皿并进行标记处理,在送往细菌室进行48小时的培养后读取结果。
空气培养皿需要开皿后暴露5分钟,然后培养48小时后进行读数。以下是详细解暴露时间:空气培养皿在三类环境空气培养标准下,需要开皿后暴露5分钟。这是为了让空气中的微生物充分沉降到培养皿的培养基上。培养时间:暴露完成后,将培养皿密封并进行培养,培养时间为48小时。
关于空气培养皿需要放置多长时间呢和空气培养皿需要放冰箱吗的介绍到此就结束了,不知道你从中找到你需要的信息了吗 ?如果你还想了解更多这方面的信息,记得收藏关注本站。
(图片来源网络,侵删)
本文可能通过AI自动登载或用户投稿,文章仅代表原作者个人观点。本站旨在传播优质文章,无商业用途。如侵犯您的合法权益请联系删除。